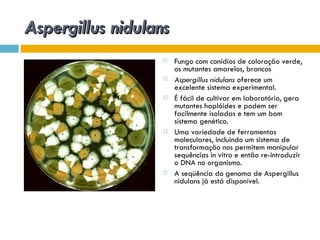
Aspergillus nidulans
                      Fungo com conídios de coloração verde,
                       os mutantes amarelos, brancos
                      Aspergillus nidulans oferece um
                       excelente sistema experimental.
                      É fácil de cultivar em laboratório, gera
                       mutantes haplóides e podem ser
                       facilmente isoladas e tem um bom
                       sistema genético.
                      Uma variedade de ferramentas
                       moleculares, incluindo um sistema de
                       transformação nos permitem manipular
                       sequências in vitro e então re-introduzir
                       o DNA no organismo.
                      A seqüência do genoma de Aspergillus
                       nidulans já está disponível.

O documento discute como as mutações em microrganismos geram variabilidade e contribuem para a evolução. As principais formas de variação genética incluem mutações, recombinações e aquisição de novos genes. Os mutantes auxotróficos, resistentes a antibióticos e com alterações morfológicas são úteis para estudos genéticos de microrganismos.